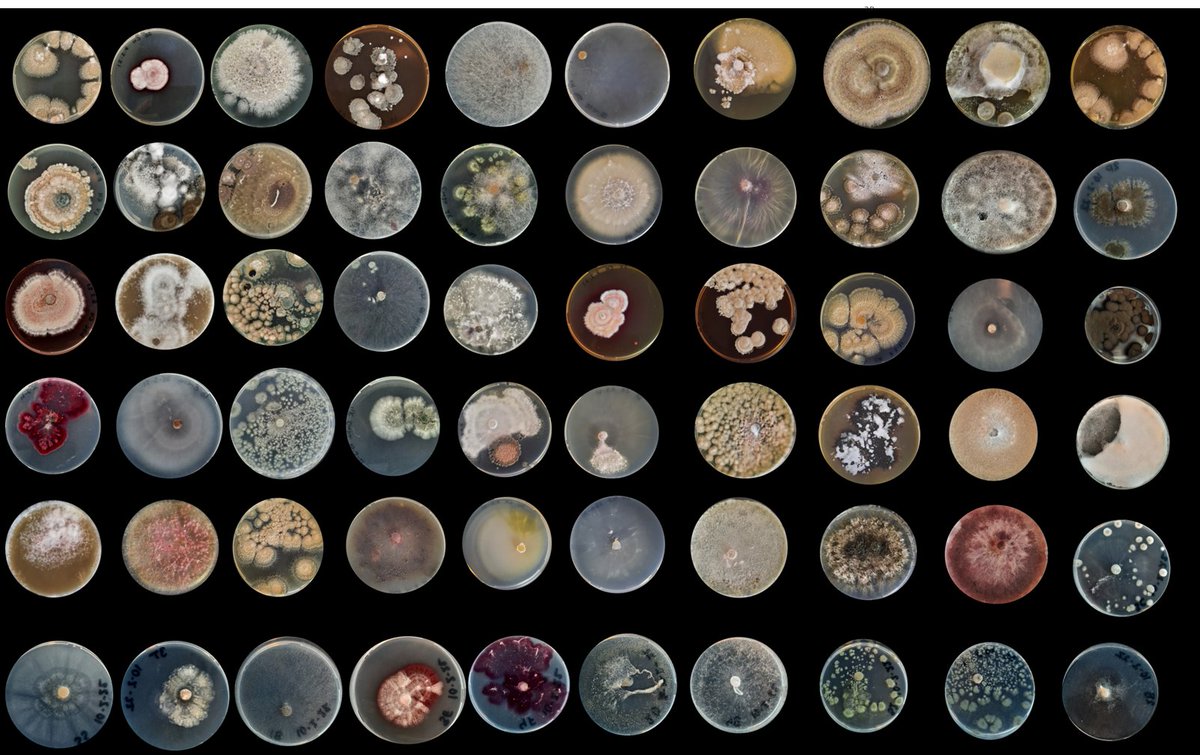
Emilia Hannula (@e_hannula) on Twitter photo Do you love fungi? Or at least like them enough to spend few years studying their traits in more detail?  I am offering a 2-year post-doc position in my group working on my Vidi project on fungal traits and soil functions. Apply before April 28th! universiteitleiden.nl/vacatures/2024… Do you love fungi? Or at least like them enough to spend few years studying their traits in more detail?  I am offering a 2-year post-doc position in my group working on my Vidi project on fungal traits and soil functions. Apply before April 28th! universiteitleiden.nl/vacatures/2024…

Stuart Fraser
@sfraser2008
Ecology and Environment Research Group Leader and Forest Pathologist @scion_research. Interested in forest ecology, management and resilience.
ID: 716914206147231744
https://scholar.google.co.uk/citations?user=FkhbCyYAAAAJ&hl=en 04-04-2016 09:04:01
538 Tweet
916 Followers
1,1K Following

Fantastic plenary talks coming up at the NZES virtual event tomorrow - come along to a hub/tune in online to hear Prof Phil Hulme, Prof Euan Ritchie and Assoc Prof John Morgan speak, along with a student plenary by James Roberts! Plenary talk details: newzealandecology.org/nzes-conferenc…

Looking for a #PhD in #Forest #Ecology? Look no further! Exciting opportunity looking at tree diversity and forest resilience currently available! 👇🌳🌲 Forest Ecology Group European Forest Institute (EFI) Resilience Programme envision-dtp.org/2023/biodivers…

I'm looking forward to spending the next two weeks Scion Research in beautiful Rotorua, NZ to conduct experiments with Stuart Fraser and team on RNA-mediated control of myrtle rust!



FOREST PATHOLOGY ASSISTANT PROFESSOR Tenure-track research & teaching position at the University of Florida. This is an open, global search. explore.jobs.ufl.edu/en-us/job/5295… Florida is a mycologist paradise, Gainesville is a great town to live in. UF School Forest, Fisheries, & Geomatics Sciences UF IFAS Solutions The American Phytopathological Society






WANTED: POPLAR RUST If your poplar trees are showing discoloration, & rust-like spots, we want to hear from you for #research into aerial transport of tree #pests & #diseases. If you can donate symptomatic poplar leaves contact [email protected]. #bayofplenty #waikato



Remember to enter the Beyond Myrtle Rust #poetry #competition. Here's our Haiku entry 🌱Seen some myrtle rust? Report it and remove it Help us slow the spread🌱 Want to learn more? Register for this #myrtlerust webinar hosted by Scion's Heidi Dungey tinyurl.com/yc2mywzj


Join us Wednesday for our monthly webinar! 🤝Te Rātā Whakamaru: community-science solutions for employment and myrtle rust resistance 🌿Presenter: Heidi Dungey Scion Research 🕚21 February 2024, 11am NZST Register to attend/access recording later: bit.ly/3qWXc92




When the funding stops, the urgency of critical issues fade from memory. Read this snapshot on the complicated state of myrtle rust research & plant conservation in New Zealand. Featuring work from Scion Research This is a pandemic we shouldn't forget! nzgeo.com/stories/the-fo…


Great myrtle rust feature in New Zealand Geographic! We’re thrilled that award-winning science journalist @ellerykr chose to apply her skillful storytelling to a subject so close to our hearts. Wonderful to see Beyond Myrtle Rust voices in the mix. Article here: bit.ly/3Wh7Okq